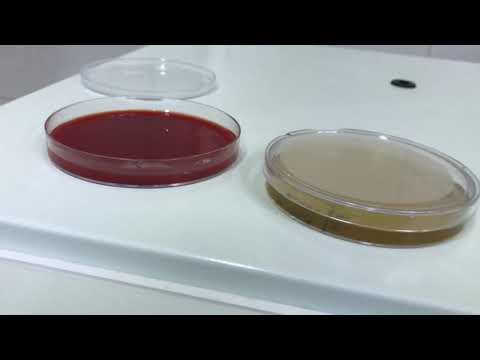
Video Thumbnail

Как определить бактериальную загрязненность воздуха (2020).

About
No channel description available.
Latest Posts
No results found. Try different keywords.
Video Description
Новое видео по практическим микробиологическим методикам. На этот раз мы разберемся, как можно определить степень бактериальной обсемененности воздуха. Вы узнаете, какие методы существуют для этих целей, а также сами увидите, как определяют бактериальную загрязненность воздуха помещений методом седиментации. В данном случае мы будем определять бактериальную загрязненность в боксе бактериологической лаборатории. Данное исследование по определению бактериальной загрязненности воздуха необходимо проводить в специализированной микробиологической лаборатории, имеющей соответствующее оснащение и расходные материалы. Бактериальное загрязнение воздуха в закрытых помещениях создает предпосылки для возникновения инфекционных заболеваний. В баклабораториях загрязненный воздух является причиной загрязнения (контаминации) питательных сред, бак. посевов. Поэтому выявление бак. загрязненности имеет большое практическое значение. Посев воздуха методом седиментации (чашечный метод) позволяет определить, какие микроорганизмы (бактерии, микроскопические грибы) присутствуют в воздухе. ******** Друзья, если это видео было полезным, в чем-то помогло вам – поддержите наш канал! https://money.yandex.ru/to/410011428040460 По этой ссылке вы можете легко сделать перевод на банковскую карту или кошелек Яндекс-Деньги, пожертвования пойдут на развитие канала. Спасибо за ваше участие! *********** Интересуетесь микробиологией? Читайте в соцсетсях "Блог микробиолога-практика Романа Овчинникова"! Фейсбук: http://fb.com/blogmicrobiologa ВКонтакте: http://vk.com/blogmicrobiologa Наш веб-сайт по лабораторной диагностике инфекций: "Бакпосев.Ру" - http://bakposev.ru #микробиологияиинфекции #микробиология #microbiology
Upgrade Your Everyday
AI-recommended products based on this video

Kasa Smart Outdoor Smart Plug by TP-Link (KP400) - Smart WiFi Outlet with 2 Sockets, IP64 Waterproof, Works with Alexa and Google Home, 2.4GHz WiFi Required, No Hub Required, Sunset & Sunrise Offset

Wireless Earbuds, Sports Bluetooth Headphones, 80Hrs Playtime Ear Buds with LED Power Display, Noise Canceling Headset, IPX7 Waterproof Earphones for Workout/Running(Black)

Wireless Earbuds, Bluetooth 5.4 Headphones HiFi Stereo with 4 HD Mic, 50H Playtime Bluetooth Earbuds with LED Display, IPX7 Waterproof Wireless Earphones, Touch Control Ear Buds,USB-C White

Wireless Earbuds, Bluetooth Ear Buds 5.4 Mini HiFi Stereo with 4 ENC Noise Cancelling Mics Wireless Headphones, in Ear Earphones 40H IP7 Waterproof, USB C, Bluetooth Earbuds for Sports, Gym, Rose

soundcore P31i by Anker, Real-Time Adaptive Noise Cancelling, Hi-Res Sound, Translation Earbuds, 50H Playtime, Wireless Earbuds, Bluetooth Earphones, Spatial Audio, Fast Charging, IP55 ClimatePartner certified

Brita Stainless Steel Premium Filtering Water Bottle, BPA-Free, Reusable, Insulated, Replaces 300 Plastic Water Bottles, Filter Lasts 2 Months or 40 Gallons, Includes 1 Filter, Carbon - 20 oz.

Simple Modern Filtered Water Bottle | Insulated Stainless-Steel Carbon Filter Travel Water Bottles | Reusable for Clean Drinking Water On The Go | 24oz, Sea Glass Sage

FITVII Health & Fitness Tracker (Answer/Make Calls), Smart Watch with 24/7 Heart Rate and Blood Pressure, Sleep Tracking Monitor, 120+ Sport Mode Activity Tracker

AYATAHA AYATAHA Smart Watch for Kids, Smartwatch Fitness Tracker for Boys Girls, Children's Activity Watch 37 Sports Modes SMS Notification, HD Full Touchscreen IP67 Waterproof, Blue

Iaret Iaret Smart Watch for Women, 1.83" HD Fitness Tracker with 4 Bands, Answer/Make Calls, Heart Rate/Sleep/SpO2/Step Tracking, 100+ Sport Modes, Android/iPhone Compatible Gift (Rose Gold)

Smart Watch for Men Women 1.8" Fitness Tracker, Bluetooth Call, DIY Dial, Heart Rate Sleep Blood Oxygen Monitor, 100+ Sports Modes, IP68 Waterproof Smartwatch for Android iPhone, Alexa Built-in

Hand Warmers 2 Pack, 14000mAh Rechargeable Hand Warmers, Electric Hand Warmer Reusable, Portable Power Bank USB Hand Warmers 4 Levels 8 Heating, Gifts for Raynauds Ski Golf Camping

Hand Warmers Rechargeable, 10000mAh Electric Heated Gloves Power Bank Portable Graphene Handwarmers Pouch with 3 Levels & Double-Sided Heating for Hunting Camping Golf Xmas Gifts for Women Men Kids

2Pack Rechargeable Hand Warmer, 8000mAh Electric Hand Warmer Power Bank, Portable USB-C Hand Warmer for Pocket, Reusable Hand Warmer Up to 8 hrs Each, Warm Gift for Men Women, for Hunting, Camping

GTOCE Portable Charger,40000mAh Power Bank with 22.5W Fast Charging LED Digital Display Battery Pack with 6 Outputs 2 Inputs, Type C Powerbank Portable Charger for iPhone 16 pro Samsung AirPods,Black

YMZ Smart Watch for Men Women, IP68 Waterproof, Bluetooth Calling, Fitness Tracker, Sleep Monitoring, 1.85'' DIY Dial, AI Built-in, 100+ Sports Modes, 7 Days Battery, Compatible with Android & iPhones

Smart Watch for Men Women 1.8" Fitness Tracker, Bluetooth Call, DIY Dial, Heart Rate Sleep Blood Oxygen Monitor, 100+ Sports Modes, IP68 Waterproof Smartwatch for Android iPhone, Alexa Built-in

Smart Watch for Men Women with Bluetooth Call, Alexa Built-in, Heart Rate & Sleep Monitor, 1.83" DIY Dial Fitness Watch with 100+ Sport Modes, IP68 Waterproof, Compatible with Android iOS

Smart Watch for Men Women with Bluetooth Call, Alexa Built-in, Heart Rate & Sleep Monitor, 1.83" DIY Dial Fitness Watch with 100+ Sport Modes, IP68 Waterproof, Compatible with Android iOS

Hydroponics Growing System Indoor Garden - Herb Garden with Grow Light, 15 Pods Stainless Steel Indoor Garden Kit, Auto Timer, Gardening Gift for All Ages

Umbra Triflora Hanging Planter for Window, Indoor Herb Garden, Set of 5, White/Black

Large Hydroponics Growing System 14 Pods, Indoor Herb Garden with LED Grow Light, 5L Water Tank, Hydroponic Grow Kit with 3 Auto-Timers, Rotatable Light Panel and Child Lock for Home School Gardening

Hanging Planter Hanging Plant Holder, 6 Inch 4 Indoor Plant Pots, Wall/Window Plant Hanger Indoor Herb Garden

Ninja Air Fryer Pro 5-in-1, 5 QT Capacity, Air Fry, Bake, Roast, Reheat, and Dehydrate, Air Crisp Technology, Nonstick Basket & Crisper Plate, Grey, AF142C

Glass Oil Sprayer for Cooking, 180ml Olive Oil Sprayer Bottle with Brush, Olive Oil Spray Mister, Kitchen Gadgets Accessories for Air Fryer, Canola Oil Spritzer (GREY)

Hi.FANCY Portable Laptop Stand with Dual Cooling Fans for 14-17inch Laptops, Grey, 23.5 x 25.9 x 0.95cm

Laptop Stand for Desk, Adjustable Laptop Riser ABS+Silicone Foldable Portable Laptop Holder, Ventilated Cooling Notebook Stand for 10-15.6” Laptops,Tablet-Black

JETech 5 in 1 Case for Samsung Galaxy S25 Ultra 5G with 2-Pack Each Tempered Glass Screen Protector and Camera Lens Protector, Non-Yellowing Shockproof Bumper Phone Cover (Clear)

TAURI for iPhone 17 Pro Max Case 6.9" with 1-Pack Screen Protector, Camera Lens Full Protection, Military-Grade Protection, Shockproof Transparent Back Bumper Phone Cover - Clear Global Recycled Standard

TAURI for iPhone 17 Pro Case 6.3" with 1-Pack Screen Protector, Camera Lens Full Protection, Military-Grade Protection, Shockproof Transparent Back Bumper Phone Cover - Clear Global Recycled Standard

JOINPAYA 1Set Rechargeable Hand Warmer Hand Heater for Winter Heating Levels Compact

Shakven Rechargeable Hand Warmer | Cute Comfortable Portable Hand Warmers,Ergonomic Adjustable Energy-Efficient Small Heater for Travel, Outdoor, Winter

OCOOPA IP45 Waterproof Hand Warmer Rechargeable, Up to 15hrs Heat,10000mAh Durable Quick Charge Electric Hand Heater, PD Compatible, 3 Levels for Outdoors, Heavy Duty, H01-PD PRO